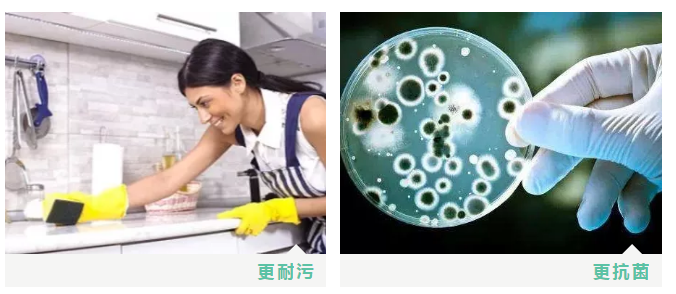

E-mail:cngkcc@qq.com 联系电话:0757-26622246 地 址:广东省佛山市南海区大沥镇岭南路77号华鸿广场20楼17-20室 发布日期:2019-10-30 11:21 来源:
EBPP焕代系列产品

一种异于常规的饰面材料!
何为科技的力量?

EB技术,利用电子加速器产生的低能电子束引发树脂聚合或交联固化,使物体表面瞬间形成强韧的涂膜树脂层,从而优化产品表面性能。
EB表面处理技术极具杀伤性优势,低能电子射线,低能耗,无环境污染。天安新材技术研发团队历时7年,击破各项EB国际技术/材料壁垒,将此技术应用于高端环保装饰材料的表面优化处理,产品性能明显优于日德同系产品!
【真实,稳定,耐用,无污染】
何为艺术的升级?
EBPP焕代系列产品自主开发的表面涂层处理技术让产品表达方式更丰满,独特的表面处理技术赋予了产品生命的气息,手指触及之处尽是自然之物的触觉,自然真实。
高精度的印刷技术,取之自然的原物扫描,同时克服了天然木材上的虫眼、节疤等缺陷,把材料最完美的一面精准呈现,可满足设计师对材料真实性的需求,花色细腻,媲美真木,更优于真木。
与传统木皮对比
表面EB涂层处理,环保系数高
高精度,以假乱真,木纹完美呈现
无自然花色缺陷,触感细腻
PUR胶平贴包覆,适合工业化生产
比传统木皮更具性价比!
...
超精尖的技术支持+高逼格的艺术细胞成就行业内超水准的
高端环保饰面材料!
部分产品花色推荐

以假乱真的木饰面质地,无论被应用于空间的每一个角落,彼此之间,既是独立的个体,又被潜移默化地融合在整个空间里。

核心技术,带来质感生活,焕代EBPP系列全线产品适用于全屋空间的护墙板、定制柜体、室内门等领域,以简约自然的气质,成为空间最靓丽的风景线!
相关推荐
咨询热点
友情链接